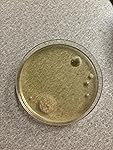

Mold Armor Do It Yourself Mold Test Kit, Test Surface Mold, Air Quality, and HVAC, Safe and Easy to Use, DIY at Home Mold Kit, Effective Both Indoors and Outdoors







Buy Now, Pay Later
- – 4-month term
- – No impact on credit to apply
- – Instant approval decision
- – Secure and straightforward checkout
Ready to go? Add this product to your cart and select a plan during checkout.
Payment plans are offered through our trusted finance partners Klarna, Affirm, Afterpay, Apple Pay, and PayTomorrow. No-credit-needed leasing options through Acima may also be available at checkout.
Learn more about financing & leasing here.
Selected Option
This item is eligible for return within 30 days of receipt
To qualify for a full refund, items must be returned in their original, unused condition. If an item is returned in a used, damaged, or materially different state, you may be granted a partial refund.
To initiate a return, please visit our Returns Center.
View our full returns policy here.
Recently Viewed
Size: 1 Count (Pack of 1)
Style: Test Kit
Features
- FIND MOLD FAST: This MOLD ARMOR Do It Yourself home mold test safely and easily tests for the presence of mold with visible results in as little as 48 hours.
- FOR INDOOR AND OUTDOOR TESTING: The Do It Yourself Mold Test Kit can be used for indoor or outdoor mold testing. Tests indoor air quality for unseen mold in the home.
- THREE TESTING METHODS: (1) Indoor Air Quality Test Method (2) Air Conditioning & Heating Sample Method (3) Surface Sampling Testing Method (when visible mold is present).
- INCLUDES EVERYTHING YOU NEED: Each air mold tester and mold kit contains a petri dish, swab, and mold growth medium.
- OPTIONAL LAB ANALYSIS: For an additional fee, mail in the results and let a team of trusted and certified US-based microbiologist professionals help you determine the mold type.
Description
The MOLD ARMOR Do It Yourself Mold Test Kit for home will safely and easily test for the presence of inside or outside mold with results within 48 hours. This convenient mold detector for home also serves as an air quality monitor and includes three testing methods: Indoor Air Quality Test Method, Air Conditioning & Heating Sample Method, and a Surface Sampling Testing Method when visible mold is present. This air quality test kit can also be used to detect unseen mold in the home. Each at-home mold air test kit contains a petri dish, swab, and mold growth medium. This mold testing kit also includes an option for mail-in lab analysis to determine the mold type. While this mold detection kit can be an important part of assessing your family’s potential exposure to mold, many factors contribute to any test’s effectiveness. The mold test kit can only detect airborne or surface mold spores, depending on test method, that are present in the area during testing. If symptoms of mold exposure persist, consult a certified mold specialist. Follow directions carefully and keep out of reach of children. From the Manufacturer Now there is a fast, easy, affordable and safe solution to fighting mold problems. Mold Armor is the proven effective product line dedicated solely to finding, cleaning and preventing mold and mildew stains on the inside and outside of your home. Protect, renew and restore your home's beauty with Mold Armor. Mold Blockers prevent mold and mildew from growing for up to 2 months.
Brand: Mold Armor
Style: Test Kit
Color: Green
Product Dimensions: 1.3"D x 5.1"W x 7"H
Global Trade Identification Number: 02
Material: Paper
Number of Items: 1
Manufacturer: Mold Armor
UPC:
Brand: Mold Armor
Style: Test Kit
Color: Green
Product Dimensions: 1.3"D x 5.1"W x 7"H
Global Trade Identification Number: 02
Material: Paper
Number of Items: 1
Manufacturer: Mold Armor
UPC: 075919005002
Part Number: FG500
Item Weight: 2.46 ounces
Item model number: FG500
Is Discontinued By Manufacturer: No
Size: 1 Count (Pack of 1)
Item Package Quantity: 1
Number Of Pieces: 1
Batteries Included?: No
Batteries Required?: No
Date First Available: September 7, 2009
Frequently asked questions
To initiate a return, please visit our Returns Center.
View our full returns policy here.
- Klarna Financing
- Affirm Pay in 4
- Affirm Financing
- Afterpay Financing
- PayTomorrow Financing
- Financing through Apple Pay
Learn more about financing & leasing here.
Similar Products
Top Amazon Reviews